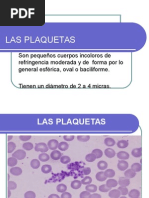

0% encontró este documento útil (0 votos)
308 vistas13 páginasLeucemia Prolinfocítica: Guía Clínica
La LP es una enfermedad de la vejez. La mediana de edad de los pacientes es de unos 70 años, con un predominio de los varones.
El pronóstico es malo, con una mediana de supervivencia de 2 años, especialmente en las de células T.
Cargado por
Ipiales AstriidDerechos de autor
© © All Rights Reserved
Nos tomamos en serio los derechos de los contenidos. Si sospechas que se trata de tu contenido, reclámalo aquí.
Formatos disponibles
Descarga como PDF, TXT o lee en línea desde Scribd
0% encontró este documento útil (0 votos)
308 vistas13 páginasLeucemia Prolinfocítica: Guía Clínica
La LP es una enfermedad de la vejez. La mediana de edad de los pacientes es de unos 70 años, con un predominio de los varones.
El pronóstico es malo, con una mediana de supervivencia de 2 años, especialmente en las de células T.
Cargado por
Ipiales AstriidDerechos de autor
© © All Rights Reserved
Nos tomamos en serio los derechos de los contenidos. Si sospechas que se trata de tu contenido, reclámalo aquí.
Formatos disponibles
Descarga como PDF, TXT o lee en línea desde Scribd